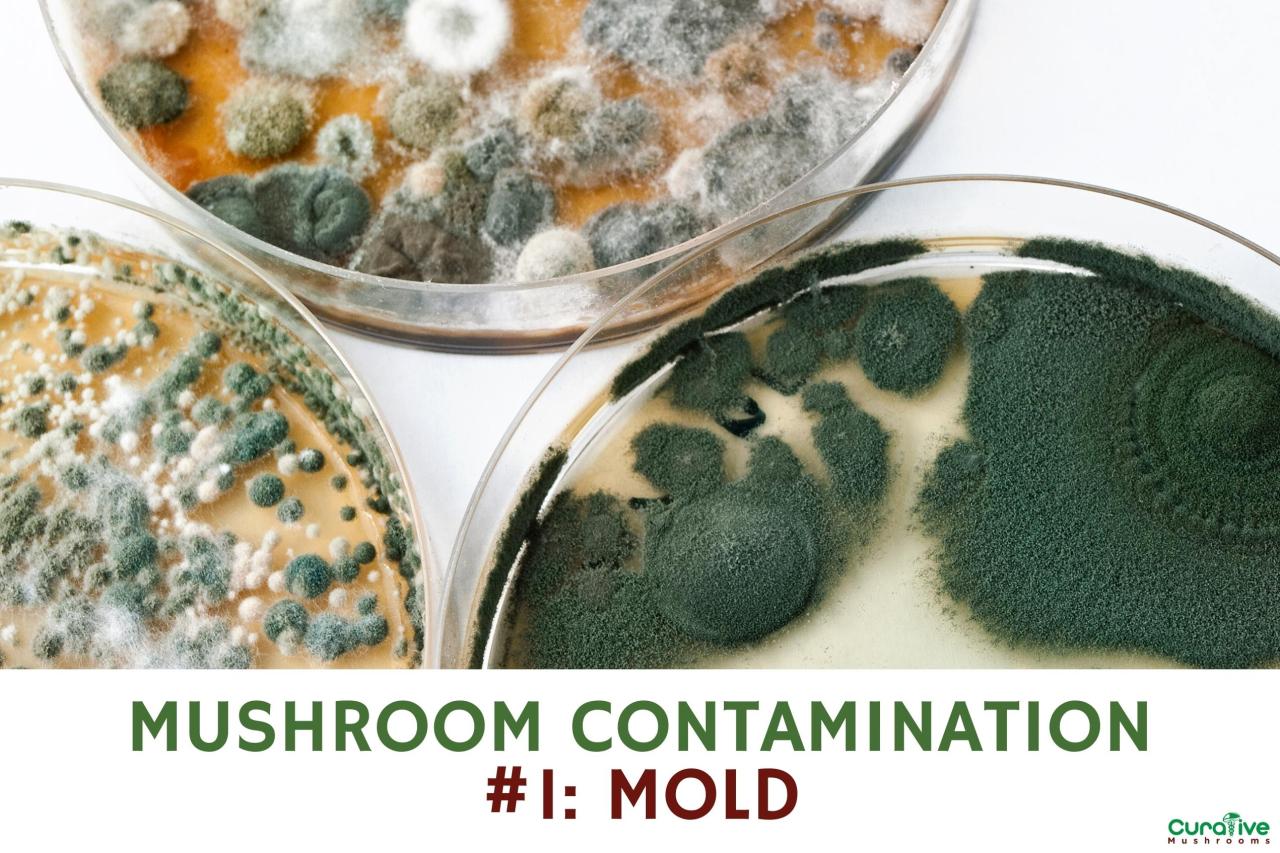
Is this contamination? : r/Mushroom_Cultivation Is this contamination? : r/Mushroom_Cultivation

How to Prevent Contamination in Mushroom Cultivation offers a comprehensive guide to safeguarding your precious fungal crops. This journey delves into the critical aspects of maintaining a pristine environment, from understanding the microscopic adversaries to implementing robust sterilization and sanitation protocols. We will explore the intricate details of substrate preparation, environmental control, and the essential tools that form the backbone of a successful, contamination-free cultivation operation.
Navigating the complexities of mushroom cultivation requires a keen understanding of the factors that can compromise your harvest. This guide is meticulously designed to equip you with the knowledge and practical strategies needed to identify, prevent, and manage contaminants effectively. By mastering these principles, you will significantly enhance your chances of achieving healthy, abundant yields and cultivating with confidence.
Understanding Contamination in Mushroom Cultivation
Preventing contamination is paramount to successful mushroom cultivation. Contaminants are unwanted microorganisms that compete with your chosen mushroom species for resources, often leading to reduced yields, poor quality mushrooms, or complete crop failure. Understanding the nature of these invaders is the first crucial step in building an effective defense.Fungal and bacterial contaminants thrive in environments that are also conducive to mushroom mycelial growth.
This overlap in ideal conditions necessitates meticulous control over the cultivation environment and processes to favor the desired organism. Vigilance and proactive measures are key to safeguarding your grow.
Common Types of Contaminants
A variety of microorganisms can pose a threat to mushroom cultivation. Recognizing these common culprits will help in identifying and mitigating their presence.
- Mold Species: These are perhaps the most frequently encountered contaminants. Common examples include:
- Trichoderma (Green Mold): Characterized by its rapid growth and vibrant green color, it aggressively outcompetes mushroom mycelium.
- Penicillium (Blue/Green Mold): Often appears as fuzzy blue or green patches and can also hinder mycelial development.
- Aspergillus (Black Mold): While less common in typical mushroom substrates, it can appear as black, powdery patches.
- Bacteria: Bacterial contaminants can manifest in various ways, often causing mushy or slimy textures.
- Bacterial Blotch: Affects the fruiting bodies, causing discolored and slimy patches.
- Sour Rot: A general term for bacterial infections that can cause a foul odor and mushy substrate.
- Other Fungi: Beyond the common molds, other fungal species can appear, sometimes with less distinctive visual cues but still detrimental to the cultivation process.
Ideal Environmental Conditions for Fungal Growth and Contaminant Inhibition
The delicate balance of environmental factors is critical. While mushrooms require specific conditions to thrive, these same conditions can also inadvertently support contaminant growth if not carefully managed.
The ideal environment for mushroom mycelial growth often shares characteristics with environments favorable to many contaminants. Therefore, precision in controlling these factors is essential for selective cultivation.
To promote the growth of your desired mushroom species while inhibiting contaminants, consider the following:
- Temperature: Each mushroom species has an optimal temperature range for both colonization and fruiting. Maintaining these specific temperatures, often through controlled heating or cooling systems, is vital. Contaminants may have different optimal temperature ranges, and by staying within the ideal range for your mushrooms, you can sometimes create a less favorable environment for some invaders.
- Humidity: High humidity is generally required for mushroom fruiting. However, stagnant, overly humid air can also promote mold and bacterial growth. Proper ventilation is key to managing humidity without creating dry spots.
- Air Exchange (Fresh Air Exchange – FAE): Mushrooms require fresh oxygen and the removal of CO2. Adequate FAE is crucial for healthy development. Insufficient FAE can lead to an accumulation of CO2, which can stress the mushroom mycelium and make it more susceptible to contamination, while also potentially favoring certain anaerobic bacteria.
- Light: While most mushroom mycelium does not require light for colonization, fruiting bodies often do. The type and intensity of light can influence development.
- Substrate pH: The pH of the growing medium plays a significant role. Many mushroom species prefer a slightly acidic to neutral pH. Certain contaminants may thrive at different pH levels, so maintaining the correct substrate pH is a form of biological control.
Primary Sources of Contaminant Introduction
Contaminants can be introduced at virtually any stage of the cultivation process. Awareness of these entry points allows for targeted preventative measures.The most common pathways for contaminants to enter your cultivation environment include:
- Airborne Spores: Molds and bacteria reproduce by releasing microscopic spores into the air. These spores are ubiquitous and can easily enter your grow space through open windows, doors, or ventilation systems if not filtered.
- Improperly Sterilized or Pasteurized Substrate: The growing medium itself is a prime source if it has not been adequately sterilized or pasteurized to eliminate competing microorganisms. Even a slight lapse in this crucial step can allow contaminants to establish themselves before the mushroom mycelium can colonize.
- Contaminated Tools and Equipment: Any surface or tool that comes into contact with your cultivation materials can carry contaminants. This includes containers, inoculation loops, scalpels, spray bottles, and even your hands.
- Human Error and Poor Hygiene: Inadequate handwashing, wearing contaminated clothing, or touching your face or hair while working with your cultures can introduce a wide array of microorganisms.
- Contaminated Spawn or Mother Culture: If the initial spawn or mother culture used for inoculation is already contaminated, the problem will inevitably spread throughout the entire cultivation.
- Pests: Insects and other pests can act as vectors, carrying fungal spores and bacteria from one area to another.
Visible Signs and Early Indicators of Common Contaminants
Early detection is vital for managing contamination. Recognizing the visual cues of common contaminants allows for prompt intervention, potentially saving your crop.Pay close attention to the following indicators:
- Coloration:
- Green, blue, or black fuzzy patches often indicate mold growth (e.g., Trichoderma, Penicillium, Aspergillus).
- Yellow or orange slime on the substrate can suggest bacterial contamination.
- Texture:
- A slimy or wet appearance on the substrate or mycelium is a strong indicator of bacterial activity.
- Dry, powdery patches, especially if accompanied by discoloration, can signal mold.
- Odor:
- A sour, vinegary, or unpleasant ammonia-like smell emanating from the substrate is often a sign of bacterial spoilage. Healthy mushroom mycelium typically has a mild, earthy, or mushroomy scent.
- Mycelial Growth Patterns:
- Contaminant molds often grow much faster and more aggressively than mushroom mycelium, appearing as distinct, rapidly expanding patches.
- Areas of stalled or stunted mycelial growth, especially if surrounded by rapid green or blue growth, suggest competition.
- Fruiting Body Abnormalities:
- Discolored spots, slimy patches, or stunted and malformed mushrooms can be signs of contamination affecting the fruiting stage.
Sterilization and Sanitation Protocols

Preventing contamination in mushroom cultivation hinges on rigorous sterilization and sanitation. These practices create a hostile environment for competing microorganisms, ensuring your chosen mushroom species thrives. This section will detail the essential protocols for achieving and maintaining a sterile growing environment.Maintaining a sterile environment is paramount. It involves a multi-faceted approach, encompassing everything from preparing your substrate to the daily upkeep of your grow space.
Adhering to these protocols significantly increases your chances of a successful harvest.
Step-by-Step Substrate Sterilization Procedure
The preparation of your substrate is a critical first step in preventing contamination. Sterilization eliminates any existing microorganisms that could outcompete your mushroom spawn. A common and effective method for home or small-scale cultivation is using a pressure cooker.Before beginning, ensure you have your chosen substrate (e.g., grain, sawdust, coir, vermiculite) prepared according to your specific mushroom species’ requirements. It should be hydrated to the correct moisture content.
- Preparation of Jars or Bags: Fill your sterilization containers (jars with modified lids or autoclavable grow bags) with the prepared substrate. Do not pack the substrate too tightly, as this can impede gas exchange and steam penetration. Leave about an inch of headspace at the top.
- Sealing Containers: Securely seal the jars with their lids, ensuring any filter patches or injection ports are properly installed. For grow bags, seal them according to the manufacturer’s instructions, often with a heat sealer or by folding and taping.
- Placing in Pressure Cooker: Arrange the filled and sealed containers in the pressure cooker. Ensure they are not overcrowded, allowing for even steam circulation. Add the recommended amount of water to the bottom of the pressure cooker.
- Pressure Cooking: Close the pressure cooker lid securely. Bring the cooker up to the desired pressure (typically 15 PSI for most common pressure cookers). Once the target pressure is reached, start your timer. The recommended sterilization time varies depending on the substrate type and volume, but 90 minutes to 2 hours is a common range for grain-based substrates in pint jars.
For larger volumes or denser substrates, longer times may be necessary.
- Cooling Down: After the sterilization period, turn off the heat and allow the pressure cooker to cool down naturally. Do not force-cool it by running cold water over it, as this can cause jars to crack and potentially create a vacuum that pulls in contaminants. Wait until the pressure gauge returns to zero and the lid can be safely opened.
- Inspection: Once cooled, carefully remove the containers from the pressure cooker. Inspect them for any signs of damage or leaks. Allow them to cool completely to room temperature before proceeding to inoculation.
Personal Hygiene and Protective Gear
The cultivator’s hands and clothing are significant vectors for introducing contaminants into the sterile environment. Implementing strict personal hygiene practices and utilizing appropriate protective gear is non-negotiable.Your body harbors a vast array of microorganisms, many of which are harmless to humans but detrimental to mushroom cultures. Therefore, minimizing the transfer of these microbes is crucial.
- Handwashing: Thoroughly wash your hands with soap and hot water for at least 20 seconds before and after any handling of substrates, cultures, or equipment. Consider using an alcohol-based hand sanitizer (at least 70% isopropyl alcohol) after washing for an extra layer of protection.
- Gloves: Always wear disposable nitrile or latex gloves when working with sterile materials. Change gloves frequently, especially if you touch non-sterile surfaces or if they become contaminated.
- Face Mask: Wear a clean face mask to prevent the expulsion of airborne bacteria and fungal spores from your breath onto your cultures.
- Arm/Hair Coverings: Consider wearing a lab coat or clean, long-sleeved shirt and hairnets or a cap to cover any stray hairs.
- Clean Clothing: Wear dedicated clean clothing for your cultivation activities. Avoid wearing the same clothes you wear outdoors or in other potentially contaminated environments.
Effective Methods for Sanitizing Cultivation Spaces and Equipment
Sanitation extends beyond substrate sterilization to encompass the entire cultivation area and all tools used. A clean environment significantly reduces the likelihood of airborne or surface-borne contaminants affecting your grow.Regular and thorough sanitization protocols for your grow room and equipment are vital for maintaining a healthy culture. This involves a combination of cleaning and disinfecting.
Sanitizing Cultivation Spaces:
The grow room itself needs to be a controlled environment. Regular cleaning and disinfection protocols are essential.
- Initial Cleaning: Before setting up your grow, thoroughly clean all surfaces, walls, floors, and ceilings. Remove any dust, debris, or organic matter.
- Disinfection: After cleaning, disinfect all surfaces using an appropriate disinfectant. Common choices include:
- Isopropyl Alcohol (70%): Effective against many bacteria and fungi. Spray surfaces and allow them to air dry.
- Bleach Solution (1:10 ratio of household bleach to water): A potent disinfectant, but ensure good ventilation and rinse surfaces if direct contact with cultures is a concern.
- Hydrogen Peroxide (3%): A good option that breaks down into water and oxygen, leaving minimal residue.
- Commercial Disinfectants: Look for products specifically designed for laboratory or horticultural use.
- Air Filtration: Consider using HEPA filters in your ventilation system to continuously remove airborne contaminants from the grow room.
- Regular Cleaning: Establish a routine for wiping down surfaces and cleaning spills immediately.
Sanitizing Equipment:
All equipment that comes into contact with your mushroom cultures or substrates must be sterilized or sanitized.
- Tools: Sterilize tools like scalpels, tweezers, and syringes using a flame (e.g., with a butane torch) or by soaking them in isopropyl alcohol and then flaming.
- Containers: Jars, bags, and trays should be thoroughly washed and then sterilized using methods like autoclaving or pressure cooking.
- Fans and Filters: Regularly clean and, if possible, sterilize or replace filters in fans and ventilation systems.
- Shelving and Surfaces: Wipe down all shelving and work surfaces with disinfectant before and after each cultivation cycle.
Daily Sanitation Routine Checklist for a Mushroom Grow Room
A consistent daily routine is the backbone of a contamination-free cultivation space. This checklist provides a framework for maintaining a high level of sanitation.Implementing a daily checklist ensures that no critical sanitation steps are overlooked, fostering a consistently clean environment.
| Task | Frequency | Notes/Disinfectant Used | Completed (Y/N) |
|---|---|---|---|
| Wipe down all work surfaces (tables, counters) | Daily (before and after use) | 70% Isopropyl Alcohol or Disinfectant Spray | |
| Inspect grow bags/jars for any signs of contamination (discoloration, unusual growth) | Daily | Visual inspection | |
| Clean up any spills or debris immediately | As needed | Appropriate cleaning solution | |
| Wash hands thoroughly before and after any work in the grow room | Before/After each session | Soap and water, then 70% Isopropyl Alcohol | |
| Check and clean air filters (if applicable) | Daily (visual check) / Weekly (cleaning) | Vacuum or wipe with disinfectant | |
| Sanitize any tools used during the day (e.g., scalpels, tweezers) | After each use | Flame sterilization or 70% Isopropyl Alcohol soak | |
| Wipe down the exterior of the grow tent/room door | Daily | Disinfectant spray |
Comparison of Sterilization Techniques
Choosing the right sterilization method depends on your scale, resources, and the type of substrate you are using. Autoclaving and pressure cooking are two of the most effective methods for eliminating microbial life.Both autoclaving and pressure cooking utilize moist heat under pressure to achieve sterilization. The primary difference lies in their typical operating pressures and, consequently, their effectiveness and application.
- Autoclaving:
- Mechanism: Autoclaves use steam under pressure to sterilize materials. They are generally more robust and capable of reaching higher pressures and temperatures than typical kitchen pressure cookers.
- Temperature/Pressure: Commonly operate at 121°C (250°F) and 15 PSI.
- Effectiveness: Highly effective at killing all forms of microbial life, including bacterial spores, fungi, and viruses.
- Applications: Widely used in laboratories and commercial settings for sterilizing media, glassware, and equipment.
- Pros: Extremely effective, reliable for large-scale operations.
- Cons: Can be expensive, requires specialized equipment and training.
- Pressure Cooking:
- Mechanism: A standard kitchen pressure cooker operates similarly to an autoclave, using steam under pressure to sterilize.
- Temperature/Pressure: Typically reaches 121°C (250°F) at 15 PSI, though some models may vary.
- Effectiveness: Effective for sterilizing substrates for mushroom cultivation when used correctly, achieving sterilization temperatures that kill most common contaminants.
- Applications: A popular and accessible method for home cultivators to sterilize grain jars, liquid cultures, and small batches of substrate.
- Pros: More affordable and accessible for home users.
- Cons: May have smaller capacity, less precise temperature control compared to dedicated autoclaves, and potentially shorter lifespan with frequent use.
Both methods are highly effective when the correct temperature, pressure, and time are maintained. For home cultivators, a reliable pressure cooker is an excellent and cost-effective tool for achieving sterile substrates. The key is to ensure the pressure reaches and maintains 15 PSI for the recommended duration (typically 90 minutes to 2 hours, depending on substrate volume and type).
Substrate Preparation and Inoculation Best Practices
The foundation of successful mushroom cultivation lies in meticulously preparing and inoculating your substrate. This stage is where you provide the essential nutrients for your mushrooms to thrive, but it’s also a critical juncture for preventing contamination. A well-prepared and properly inoculated substrate significantly reduces the chances of unwanted organisms taking hold, ensuring a healthier and more productive mycelial growth.The substrate serves as the food source for the mushroom mycelium.
Its composition directly influences how well the mycelium can colonize and how resistant it is to competing microorganisms. Different mushroom species have varying nutritional requirements and preferences for substrate types. Understanding these needs is paramount for creating an environment that favors your chosen fungi over potential contaminants.
Substrate Composition and Contamination Resistance
The selection of substrate ingredients plays a crucial role in its inherent resistance to contamination. Certain materials are more prone to harboring bacteria and molds, while others offer a more challenging environment for them to establish. The ideal substrate provides ample nutrition for the mushroom mycelium without being overly rich, which can attract a wider array of contaminants.Key considerations when choosing substrate components include:
- Nutrient Density: While mushrooms require nutrients, excessively high levels of readily available sugars and proteins can create a breeding ground for bacteria. Balancing these with more complex carbohydrates and lignocellulosic materials can slow down bacterial growth.
- Moisture Content: The ideal moisture level is crucial. Too dry, and the mycelium struggles to grow; too wet, and it creates anaerobic conditions that favor bacterial contamination. Aim for a moisture content that feels like a wrung-out sponge.
- pH Level: Different mushroom species prefer specific pH ranges. Maintaining the correct pH can inhibit the growth of certain common contaminants that thrive in different pH environments.
- Sterilization/Pasteurization Efficacy: The chosen substrate materials must be amenable to effective sterilization or pasteurization. Some materials are more difficult to fully decontaminate than others, requiring more rigorous treatment.
Critical Factors in Substrate Selection and Preparation
Selecting and preparing the right substrate involves careful consideration of several factors to ensure optimal conditions for mushroom growth and minimal contamination risk. This process requires precision and adherence to established protocols.The following are critical factors to consider:
- Species-Specific Requirements: Research the preferred substrate composition for your specific mushroom species. For example, oyster mushrooms often thrive on sawdust and straw, while gourmet edibles like shiitake prefer hardwood sawdust.
- Ingredient Quality: Use fresh, high-quality ingredients. Avoid old, moldy, or insect-infested materials, as these already harbor contaminants.
- Particle Size: The size of the substrate particles affects aeration and moisture retention. A mix of fine and coarse particles generally provides a good balance. For sawdust-based substrates, a fine sawdust mixed with larger wood chips is often ideal.
- Supplementation: While supplements like bran or gypsum can boost yields, they also increase the nutrient load, making the substrate more susceptible to contamination. Use supplements judiciously and ensure they are thoroughly mixed and properly sterilized.
- Hydration Level: Achieving the correct hydration is one of the most critical steps. Over-hydration is a common cause of bacterial contamination. The “squeeze test” is a reliable method: when you squeeze a handful of substrate, only a few drops of water should come out.
- pH Adjustment: For some species, adjusting the pH of the substrate is beneficial. This can be done using materials like lime or gypsum, but it must be done carefully and according to specific recipes.
Best Practices for Inoculating Sterilized Substrates
Inoculation is the process of introducing mushroom spawn to the prepared substrate. This step must be performed under the strictest aseptic conditions to prevent airborne contaminants from entering the substrate and outcompeting the desired mycelium.To minimize exposure during inoculation, follow these best practices:
- Work in a Still Air Box (SAB) or Laminar Flow Hood: These controlled environments drastically reduce the number of airborne contaminants. A SAB can be easily constructed from a clear plastic storage bin.
- Sterilize All Tools and Surfaces: Before beginning, thoroughly sterilize your inoculation tools (scalpel, tweezers, syringes) with isopropyl alcohol and a flame, and wipe down all surfaces within the SAB or flow hood.
- Wear Personal Protective Equipment: Use a face mask and gloves to prevent introducing your own skin bacteria and respiratory droplets into the sterile environment.
- Minimize Air Movement: Avoid unnecessary movements that can stir up dust and spores. Keep doors and windows closed in the room where you are working.
- Rapid Inoculation: Work quickly and efficiently to reduce the time the substrate is exposed to the air.
- Proper Sealing: Once inoculated, ensure your substrate containers (bags or jars) are properly sealed with filter patches or micropore tape to allow for gas exchange while preventing contaminant entry.
Aseptic Transfer of Grain Spawn to Bulk Substrates
The transfer of colonized grain spawn to a bulk substrate is a pivotal moment in mushroom cultivation. This process requires the utmost care to ensure the healthy mycelium from the grain is not compromised by contaminants present in the bulk substrate or introduced during the transfer.The process of aseptic transfer for grain spawn to bulk substrates involves these crucial steps:
- Prepare the Bulk Substrate: Ensure your bulk substrate has been properly pasteurized or sterilized according to its specific requirements and has cooled to the appropriate temperature for inoculation (usually room temperature or slightly above).
- Sterilize Transfer Tools: Thoroughly sterilize all tools that will come into contact with the grain spawn or bulk substrate, including spatulas, scoops, and the exterior of the spawn bags/jars.
- Work in a Sterile Environment: Perform the transfer inside a Still Air Box (SAB) or Laminar Flow Hood.
- Introduce Grain Spawn: Open the grain spawn bag or jar and carefully break up the colonized grain. Add the desired amount of grain spawn to the bulk substrate. A common ratio is 1:5 to 1:10 (spawn to substrate), depending on the species and desired colonization speed.
- Thorough Mixing: Gently but thoroughly mix the grain spawn into the bulk substrate. Ensure even distribution to promote uniform colonization.
- Pack and Seal: Pack the inoculated bulk substrate into your chosen grow bags or containers. Seal them appropriately with filter patches or micropore tape to allow for air exchange while preventing contaminant ingress.
- Incubate: Place the inoculated bulk substrate in a clean, dark, and temperature-controlled incubation area.
Troubleshooting Common Contamination Issues During Substrate Preparation
Even with the best intentions and protocols, contamination can sometimes occur during substrate preparation. Identifying and addressing these issues promptly is key to salvaging your cultivation efforts.Here is a guide to troubleshooting common contamination issues:
| Contaminant Type | Appearance | Likely Cause | Troubleshooting/Prevention |
|---|---|---|---|
| Green Mold (Trichoderma) | Bright green, powdery patches, often spreading rapidly. | Incomplete sterilization/pasteurization, airborne spores, contaminated spawn. | Discard contaminated batches immediately. Improve sterilization/pasteurization times and temperatures. Work in a cleaner environment. Ensure spawn is clean. |
| Bacterial Blotch (Pseudomonas) | Slimy, yellowish or brown patches, often with a foul odor. | Over-hydration, insufficient pasteurization, poor air exchange. | Ensure proper moisture levels. Use effective pasteurization methods. Provide adequate fresh air exchange during incubation. |
| Cobweb Mold (Dactylium) | Thin, wispy, greyish-white mycelium resembling cobwebs, often covering the surface. | Low incubation temperatures, high humidity, insufficient fresh air. | Increase incubation temperature slightly. Ensure adequate air exchange. Reduce humidity if excessive. |
| Black Mold (Rhizopus) | Black, fuzzy patches, often appearing as small black dots. | High moisture content, poor hygiene, exposure to air. | Ensure proper moisture levels. Maintain strict hygiene. Minimize exposure to air. |
| Pin Molds (Various species) | Small, fuzzy spots of various colors (white, grey, brown). | Contaminated ingredients, inadequate sterilization, airborne spores. | Use fresh, clean ingredients. Ensure thorough sterilization. Work in a clean environment. |
When in doubt, throw it out. It is far better to discard a potentially contaminated batch than to risk spreading contaminants to future cultivations.
Environmental Control for Contamination Prevention
Maintaining a controlled environment is paramount in mushroom cultivation, as it directly influences the success of your grow and the prevention of unwanted contaminants. Fluctuations in temperature and humidity can create opportune conditions for mold and bacteria to thrive, outcompeting your mushroom mycelium. This section will guide you through the critical aspects of environmental control to ensure a clean and productive cultivation space.The stability of your growing environment is a cornerstone of contamination prevention.
Unpredictable shifts in temperature and humidity can stress your mycelium, making it more susceptible to invasion by opportunistic organisms. Creating a consistent and optimal atmosphere is therefore a proactive measure against contamination.
Impact of Temperature and Humidity Fluctuations on Contamination Risks
Temperature and humidity are two of the most significant environmental factors influencing the growth and proliferation of microorganisms, including both beneficial mushroom mycelium and detrimental contaminants. Unstable conditions can lead to a cascade of problems.When temperatures deviate significantly from the ideal range for your specific mushroom species, the mycelium’s growth rate can slow down. This weakened state makes it less competitive against faster-growing molds and bacteria.
For instance, a sudden drop in temperature might not kill the mycelium but can give airborne fungal spores ample time to land and germinate on the substrate surface before the mycelium can establish a robust colonization.Conversely, excessive humidity, especially when combined with poor air circulation, can create a breeding ground for bacteria and molds. High humidity can lead to condensation on surfaces, providing a water source for contaminants.
Certain molds, like Trichoderma, are particularly adept at colonizing moist environments. For example, a common scenario in amateur grows is experiencing a green mold outbreak after a period of high humidity and insufficient fresh air exchange, which allows mold spores to accumulate and find a suitable niche.
Methods for Maintaining Stable Environmental Parameters
Achieving and maintaining stable temperature and humidity levels is crucial for a healthy mushroom grow. This involves employing a combination of equipment and careful monitoring.For temperature control, consider using a reliable thermostat connected to a heater or cooler, depending on your ambient conditions. In smaller setups like a grow tent, a small space heater with a thermostat can effectively maintain a consistent temperature.
For humidity, a humidifier or a fogger, controlled by a humidistat, is essential. These devices can be programmed to activate when humidity drops below a set point and deactivate when it reaches the desired level.Effective methods for maintaining stable parameters include:
- Thermostats and Humidistats: These are essential control devices. A thermostat regulates temperature by turning heating or cooling elements on and off, while a humidistat manages humidity by controlling humidifiers or dehumidifiers. For instance, setting a thermostat to maintain 70-75°F (21-24°C) and a humidistat to keep humidity between 85-95% for fruiting mushrooms can significantly reduce contamination risks.
- Insulation: For grow rooms, proper insulation helps to buffer against external temperature fluctuations, reducing the workload on heating and cooling systems.
- Ventilation Systems: While also crucial for air exchange, controlled ventilation helps to prevent stagnant air pockets where humidity can build up excessively, contributing to condensation and contaminant growth.
- Monitoring: Regularly checking temperature and humidity gauges (digital hygrometers and thermometers are recommended for accuracy) allows for timely adjustments and ensures your control systems are functioning correctly.
- Watering Practices: Misting the walls of a grow tent or the substrate surface directly, rather than over-saturating, helps maintain humidity without creating excessive free water that encourages bacterial growth.
Importance of Air Exchange and Filtration in Preventing Airborne Contaminants
Air exchange, often referred to as fresh air exchange (FAE), is vital for removing stale air laden with CO2 and other metabolic byproducts of mushroom growth, and more importantly, for preventing the buildup of airborne contaminants. Filtration ensures that the air entering your cultivation space is clean.Without adequate air exchange, CO2 levels can rise, which is detrimental to mushroom fruiting and can also favor certain types of bacteria and molds that tolerate higher CO2 concentrations.
Stagnant air also allows airborne contaminants, such as mold spores and bacteria, to settle and proliferate on surfaces and substrates.Filtration of incoming air is a critical barrier against these microscopic invaders. HEPA (High-Efficiency Particulate Air) filters are highly effective at capturing a vast majority of airborne particles, including mold spores, bacteria, and even viruses. When setting up your ventilation, consider using inline fans with activated carbon filters to remove odors and particulate filters to clean the incoming air.
For example, a common practice is to use a filtered intake fan that pulls air through a MERV 13 or higher filter into the grow tent, ensuring that only clean air enters the system.
Effective Strategies for Managing CO2 Levels
Managing carbon dioxide (CO2) levels is a delicate balance in mushroom cultivation. While mycelial growth can tolerate higher CO2 concentrations, the fruiting stage of most mushroom species requires lower CO2 levels and increased fresh air. Elevated CO2 levels can also inadvertently support the growth of certain contaminants that thrive in such conditions.The key is to provide enough fresh air to keep CO2 within acceptable limits for fruiting without causing excessive drying of the substrate or drastic temperature drops.
For many common edible mushrooms, CO2 levels should be kept below 1000 ppm during the fruiting stage.Effective strategies for managing CO2 levels include:
- Controlled Ventilation: This is the primary method. Timed ventilation cycles, where fresh air is introduced at regular intervals, are crucial. For instance, a fan timer can be set to exchange air for 15 minutes every hour during the fruiting stage.
- Automated CO2 Monitoring: For more advanced setups, a CO2 sensor can be integrated with your ventilation system. This allows the system to automatically adjust ventilation based on real-time CO2 readings, ensuring optimal levels are maintained without over-ventilating.
- Substrate Choice: Some substrates naturally produce less CO2 during decomposition, which can help in managing levels. However, this is a less direct control method.
- Understanding Species Requirements: Different mushroom species have varying CO2 tolerances. Researching the specific needs of your chosen species is fundamental to effective management. For example, oyster mushrooms are generally more tolerant of higher CO2 during colonization than during fruiting, while species like Psilocybe cubensis require significantly lower CO2 for optimal fruiting.
“Optimal CO2 management supports healthy mushroom development while simultaneously deterring contaminant growth by creating an environment less favorable to their proliferation.”
Ventilation System Layout for a Small-Scale Mushroom Cultivation Setup
Designing an effective ventilation system for a small-scale setup, such as a grow tent or a dedicated small room, is essential for controlling temperature, humidity, and air quality. The goal is to create a consistent flow of clean air while removing stale air and excess moisture.A basic yet effective ventilation system for a small grow tent can be constructed using a few key components.
This system aims to provide both intake and exhaust of air, ensuring a constant circulation of fresh, filtered air.A typical layout for a small-scale setup might include:
- Exhaust Fan: Positioned at the top of the grow tent or room to expel warm, moist, and CO2-rich air. This fan should be connected to ducting that leads outside the cultivation area or to a carbon filter if odor control is necessary. An inline fan with a variable speed controller is ideal for fine-tuning airflow.
- Intake Fan (or Passive Intake): If using an active intake, this fan should be placed at the bottom of the tent, drawing in fresh air from outside. This fan should be fitted with a high-quality air filter (e.g., MERV 13 or HEPA) to prevent contaminants from entering. Alternatively, a passive intake can be achieved using filtered vents, allowing air to enter naturally due to pressure differences created by the exhaust fan.
- Circulation Fan: A small internal fan placed within the tent to ensure even air distribution and prevent stagnant pockets. This fan helps to mix the air, distributing temperature and humidity evenly throughout the space and preventing condensation buildup on surfaces.
- Ducting: Flexible or rigid ducting to connect the fans to the tent or room openings, and potentially to filters.
- Timers: To automate the operation of the exhaust and intake fans, ensuring consistent air exchange cycles. For example, setting the exhaust fan to run for 15 minutes every hour during fruiting.
The placement of these components is crucial. The exhaust fan should be at the highest point to remove the warmest and lightest gases (CO2, heat), while the intake should be at the lowest point to draw in cooler, fresh air. The circulation fan should be positioned to create a gentle, consistent airflow across the entire cultivation area. For a grow tent, a common setup involves an exhaust fan at the top rear, an intake fan with a filter at the bottom front, and a small clip-on fan for circulation.
This arrangement creates a natural convection current, aiding in air turnover and environmental stability.
Managing Contamination When It Occurs
Even with the most rigorous preventative measures, contamination can sometimes find its way into your mushroom cultivation project. Recognizing and responding effectively to contamination is a critical skill for any cultivator. This section will guide you through the steps to manage outbreaks, minimize losses, and learn from these challenging situations.Addressing contamination promptly and correctly is essential to protect your healthy cultures and prevent future issues.
It involves a combination of swift action, careful observation, and a commitment to learning from mistakes.
Isolating Contaminated Mushroom Cultures or Substrates
When contamination is detected, immediate isolation is paramount to prevent its spread to other cultures, substrates, or the cultivation environment. This containment strategy is a cornerstone of successful contamination management.Effective isolation techniques are designed to create a physical barrier between the contaminated material and the rest of your operation. This can be achieved through several methods:
- Physical Separation: Move the contaminated item to a designated “quarantine” area, ideally a separate room or a well-sealed container away from your main cultivation space. Ensure this area has its own ventilation if possible, or at least is kept meticulously clean.
- Aseptic Transfer (for early-stage contamination): If contamination is detected very early in a petri dish or liquid culture, it may be possible to salvage a small portion. Using a sterile scalpel or loop, carefully cut away the visibly contaminated area and transfer a small, healthy-looking section to a new, sterile petri dish or vessel. This requires extreme care and should only be attempted if the contamination is localized and minimal.
- Sealing Contaminated Items: For larger contaminated substrates like bags or tubs, seal them tightly with tape or place them inside a heavy-duty plastic bag to prevent the release of spores or microorganisms into the air.
Disposal Protocols for Heavily Contaminated Batches
For batches that are extensively contaminated, the most responsible course of action is complete disposal. Attempting to salvage heavily infected material often leads to further spread and can compromise future grows. Proper disposal prevents the proliferation of unwanted microorganisms within your cultivation space and the surrounding environment.The goal of disposal is to neutralize or contain the contaminants before they can spread.
Here are the recommended protocols:
- Bag and Seal: Place the entire contaminated substrate (e.g., bag, tub) into a heavy-duty trash bag. Seal the bag securely, removing as much air as possible. Double-bagging is often recommended for added security.
- Sterilization/Pasteurization (if possible): If you have the means, consider sterilizing or pasteurizing the sealed bag in an oven or autoclave at high temperatures before disposal. This can help kill off active contaminants.
- Outdoor Burial: For larger quantities, burying the sealed bags in a designated compost pile or a deep hole in your yard (away from your cultivation area and any food gardens) can be an effective method. The contaminants will decompose naturally over time.
- Avoid Composting with Healthy Material: Never add heavily contaminated mushroom substrates to your active compost bins that you intend to use for future cultivation or gardening.
Use of Beneficial Microorganisms as a Preventative Measure
Beneficial microorganisms, often referred to as “probiotics” for fungi, can play a significant role in outcompeting and suppressing common contaminants. By establishing a healthy population of these beneficial microbes, you create an environment less hospitable to unwanted guests.These microorganisms work through various mechanisms to protect your mushroom cultures:
- Competitive Exclusion: Beneficial bacteria and fungi can occupy available resources and colonization sites on the substrate, leaving less for contaminants to establish themselves.
- Antagonistic Production: Some beneficial microbes produce compounds that are toxic or inhibitory to common contaminants like molds and bacteria.
- pH Modification: Certain beneficial microorganisms can alter the pH of the substrate in a way that favors mushroom growth and hinders contaminant development.
Common examples of beneficial microorganisms used in cultivation include certain strains of Trichoderma species (though some species can be predatory to mushrooms, careful selection is key) and various bacterial species. They are often introduced through specialized inoculants or can be naturally present in some organic substrate components.
Identifying the Specific Contaminant in a Failed Grow
Accurate identification of the contaminant is crucial for understanding the root cause of failure and refining your prevention strategies. While visual inspection is the first step, microscopic examination and even basic culturing can provide more definitive answers.The process of identification involves careful observation and, where possible, further analysis:
- Visual Inspection: Observe the color, texture, and growth pattern of the contaminant. Common contaminants include green molds (e.g., Trichoderma), black molds (e.g., Rhizopus), bacterial blotches (often slimy and foul-smelling), and cobweb mold (wispy, gray growth). Note where it is growing and how it is spreading.
- Smell: Contaminants often have distinct odors. Moldy smells, sour smells, or ammonia-like odors can indicate specific types of contamination.
- Microscopic Examination: If you have access to a microscope, you can examine spores or hyphae of the contaminant. This is the most definitive method for identifying specific species of fungi and bacteria.
- Culturing for Identification: In some cases, a small sample of the contaminated material can be transferred to a sterile petri dish with a nutrient agar. The contaminant will grow, allowing for easier identification through visual or microscopic means. This is particularly useful for identifying bacterial contaminants that may not be easily visible on the substrate.
Documenting your observations, including photographs, can be invaluable for tracking recurring contamination issues and seeking advice from experienced cultivators.
Flowchart for Responding to the Discovery of Contamination
A systematic approach to dealing with contamination ensures that each instance is handled efficiently and consistently, minimizing potential damage and maximizing learning opportunities. This flowchart Artikels a general response strategy.
+-----------------------+
| Contamination Detected|
+-----------+-----------+
|
v
+-----------------------+
| Isolate Immediately |
| (Quarantine Area) |
+-----------+-----------+
|
v
+-----------------------+
| Assess Severity: |
|
-Minor (Localized) |
|
-Major (Widespread) |
+-----------+-----------+
|
v
+-----------------------+
| If Minor: |
|
-Attempt Salvage |
| (if feasible) |
|
-Monitor Closely |
+-----------+-----------+
|
v
+-----------------------+
| If Major: |
|
-Prepare for Disposal|
+-----------+-----------+
|
v
+-----------------------+
| Dispose Properly |
| (Bag, Seal, Neutralize|
| or Bury) |
+-----------+-----------+
|
v
+-----------------------+
| Identify Contaminant |
| (Visual, Microscopic) |
+-----------+-----------+
|
v
+-----------------------+
| Analyze Cause |
| (Sterilization, |
| Sanitation, Airflow) |
+-----------+-----------+
|
v
+-----------------------+
| Adjust Protocols |
| (Prevent Future Issues)|
+-----------------------+
Tools and Equipment for Sterile Cultivation

Maintaining a sterile environment is paramount in mushroom cultivation to prevent the introduction and proliferation of competing microorganisms.
The right tools and equipment, coupled with diligent practices, form the foundation of a successful and contamination-free grow. This section Artikels the essential items and their proper handling to ensure a sterile cultivation process.
A sterile cultivation setup relies on a combination of specialized tools and equipment designed to minimize contamination risks at every stage. From initial preparation to the final harvest, each piece plays a crucial role in safeguarding your mycelial cultures. Understanding their function and how to maintain them is key to achieving optimal yields.
Essential Sterile Tools and Equipment
To embark on a sterile mushroom cultivation journey, a well-equipped workspace is indispensable. The following list details the core tools and equipment that will serve as your primary defense against contaminants.
- Pressure Cooker or Autoclave: For sterilizing substrates and equipment at high temperatures and pressures.
- Laminar Flow Hood or Still Air Box (SAB): Creates a sterile workspace for inoculation and other sensitive procedures.
- Isopropyl Alcohol (70% or 99%): A broad-spectrum disinfectant for surfaces, tools, and hands.
- Gloves (Nitrile or Latex): Protects against contamination from your hands and prevents accidental spills.
- Face Mask: Prevents respiratory droplets from contaminating sterile environments.
- Scalpel or Blade: For precise cutting and transfer of mycelium.
- Tweezers: For handling small sterile items and transferring cultures.
- Weighing Scale: For accurate measurement of ingredients during substrate preparation.
- Storage Containers: Sterile jars, bags, or tubs for substrate and spawn.
- Syringes and Needles: For sterile liquid culture preparation and inoculation.
- Parafilm or Sealing Tape: To seal jars and containers, maintaining sterility.
- Spray Bottles: For dispensing disinfectants.
- Timer: For precise control of sterilization and incubation periods.
Cleaning and Sterilization Procedures for Reusable Cultivation Equipment
The effectiveness of your sterile cultivation hinges on the thoroughness of your cleaning and sterilization protocols for reusable equipment. Consistent application of these procedures minimizes the microbial load in your grow environment.
Reusable equipment must undergo a multi-step process to ensure it is free from contaminants. This typically begins with thorough washing to remove gross debris, followed by disinfection and, in many cases, terminal sterilization.
- Washing: All reusable equipment should be washed with hot water and a mild detergent to remove any visible dirt, organic matter, or residue.
- Rinsing: Thoroughly rinse all equipment with clean water to remove any soap residue, which can interfere with sterilization.
- Disinfection: Immerse or wipe down equipment with a solution of 70% isopropyl alcohol. Allow it to air dry or wipe dry with sterile wipes.
- Sterilization: For equipment that comes into direct contact with the substrate or culture (e.g., jars, tools), terminal sterilization is essential. This is typically achieved through a pressure cooker or autoclave. Substrate jars should be sterilized at 15 PSI for 90 minutes. Tools can be sterilized by flaming (if applicable) or by autoclaving.
Advantages and Disadvantages of Using Single-Use Sterile Consumables
The mushroom cultivation industry increasingly utilizes single-use sterile consumables, offering a distinct set of benefits and drawbacks that cultivators must weigh. These items are designed for one-time use, simplifying many sterile procedures.
Single-use items offer convenience and can significantly reduce the risk of cross-contamination, especially in larger operations or when dealing with sensitive cultures. However, their recurring cost and environmental impact are important considerations.
Advantages of Single-Use Sterile Consumables:
- Reduced Contamination Risk: Each item is sterile out of the packaging, eliminating the need for in-house sterilization and minimizing handling errors.
- Time Savings: Eliminates the need for extensive cleaning and sterilization of reusable equipment.
- Convenience: Ready to use, streamlining workflow and reducing preparation time.
- Consistency: Pre-sterilized items offer a higher degree of reliability in maintaining sterility.
Disadvantages of Single-Use Sterile Consumables:
- Cost: The recurring purchase of single-use items can represent a significant ongoing expense, especially for hobbyists or small-scale growers.
- Environmental Impact: The disposal of large quantities of plastic and packaging contributes to waste.
- Limited Availability: Some specialized single-use items may not be readily available or may be expensive to source.
Maintenance Schedule for Critical Cultivation Equipment
The reliable performance of critical cultivation equipment is vital for maintaining a stable and sterile environment. Regular maintenance ensures that these components function as intended, preventing potential failures that could lead to contamination.
Key equipment such as air filtration systems and pumps require a structured maintenance schedule to guarantee their effectiveness. Neglecting this can lead to compromised air quality and increased contamination risks.
Air Filters:
- HEPA Filters: These should be inspected regularly for visible damage or discoloration. Depending on usage and the environment, HEPA filters in laminar flow hoods or intake systems typically need replacement every 6-12 months. A visual inspection for dust buildup is a good indicator for more frequent checks.
- Pre-filters: These capture larger particles and should be cleaned or replaced more frequently, often monthly, to extend the life of the HEPA filter.
Air Pumps (for aeration systems):
- Diaphragm Pumps: These often have diaphragms that can wear out over time. Manufacturers’ recommendations for replacement vary, but inspecting for reduced airflow or unusual noise can indicate a need for service or replacement, typically every 1-3 years.
- Impellers/Motors: Ensure impellers are clean and free of debris. Lubrication (if applicable) should be checked according to the manufacturer’s guidelines.
General Equipment Checks:
- UV Sterilizers: Bulbs should be replaced annually, as their germicidal effectiveness diminishes over time, even if they still emit light.
- Incubators/Environmental Chambers: Temperature and humidity sensors should be calibrated at least annually to ensure accurate readings.
Selecting Appropriate Laboratory-Grade Equipment for Home Cultivation
While the term “laboratory-grade” might sound intimidating, it signifies equipment designed for precision, reliability, and sterile applications, which are highly beneficial for home mushroom cultivation. Choosing wisely can elevate your success rate.
For home cultivators, the goal is to find equipment that offers the necessary sterility and control without an exorbitant cost. Balancing performance with budget is key to building an effective sterile setup.
- Laminar Flow Hoods: For home use, a benchtop laminar flow hood is ideal. Look for models with a good-quality HEPA filter and a consistent airflow velocity (typically 0.5 m/s or 100 fpm). While professional lab hoods can cost thousands, consumer-grade options are available for a few hundred dollars. Alternatively, a well-constructed Still Air Box (SAB) made from a clear plastic tote can be a highly effective and budget-friendly option for basic inoculation tasks.
- Pressure Cookers: A standard stovetop pressure cooker with a capacity of at least 10-15 quarts is sufficient for sterilizing most common substrate volumes for home use. Ensure it can reliably reach and maintain 15 PSI.
- Microscopes: While not strictly essential for all cultivation, a basic compound microscope (40x-400x magnification) can be invaluable for identifying contaminants in spore syringes or liquid cultures before they become problematic in bulk substrates.
- Incubators: For temperature-sensitive species, a dedicated incubator or a modified chest freezer with a temperature controller is recommended. These allow for precise temperature regulation, preventing overheating or chilling that can hinder mycelial growth or encourage contaminants.
- Sterile Syringes and Needles: While single-use is common, investing in a few high-quality, autoclavable glass syringes and stainless steel needles can be more economical long-term if you have access to an autoclave or pressure cooker. Ensure they are thoroughly cleaned and sterilized between uses.
Advanced Contamination Prevention Strategies
Moving beyond fundamental sterilization and sanitation, advanced contamination prevention strategies involve sophisticated equipment, controlled environments, and highly specific procedural development. These methods are crucial for achieving high yields and consistent success, especially when working with sensitive species or at larger scales. By understanding and implementing these advanced techniques, cultivators can significantly minimize the risk of costly contamination events.
Laminar Flow Hoods and Sterile Work Application
Laminar flow hoods are indispensable tools for creating a sterile working environment, particularly during inoculation and other sterile transfer procedures. They function by drawing air through a HEPA (High-Efficiency Particulate Air) filter and then expelling it in a unidirectional, non-turbulent stream across the work surface. This constant flow of filtered air pushes any airborne contaminants away from the critical sterile zone, thereby protecting cultures from microbial invasion.
The application of laminar flow hoods requires strict adherence to specific operating protocols to maximize their effectiveness. This includes ensuring the hood is turned on for a sufficient pre-operation period (typically 15-30 minutes) to purge the workspace of any residual contaminants. Users should also work well within the airflow, avoiding sudden movements that could disrupt the laminar stream, and always placing materials in a way that does not obstruct the airflow from the filter to the user.
Essential items should be placed in a logical sequence to minimize reaching and potential contamination.
Negative Pressure Environments for Contaminant Ingress Prevention
Establishing negative pressure within cultivation spaces is a proactive measure to prevent the ingress of airborne contaminants from surrounding areas. A negative pressure environment means that the air pressure inside the cultivation space is lower than the air pressure in adjacent areas. Consequently, any air leakage will flow
-into* the cultivation space, carrying any potential contaminants from the less controlled external environment
-away* from the sterile internal environment.
This is typically achieved through ventilation systems that exhaust more air from the cultivation room than they supply. For example, a room might be designed to exhaust 10% more air than is introduced, creating a gentle inward flow of air through any small gaps or cracks. This is particularly vital in larger commercial operations or research facilities where maintaining pristine conditions is paramount.
Developing Custom Sterile Procedures for Unique Cultivation Projects
While standard sterile techniques are effective for many situations, unique cultivation projects, such as those involving novel substrates, rare species, or highly sensitive genetic lines, may necessitate the development of custom sterile procedures. This involves a thorough risk assessment of the specific project’s parameters and the identification of potential contamination vectors unique to that endeavor.
The process of developing custom procedures includes:
- Species-Specific Analysis: Researching the known contamination vulnerabilities of the target mushroom species. Some species are inherently more prone to specific types of contamination than others.
- Substrate Characterization: Understanding the nutritional profile and moisture content of unique substrates, as these can favor the growth of certain molds or bacteria.
- Process Mapping: Detailing every step of the cultivation process, from substrate preparation to fruiting, and identifying critical control points where contamination is most likely to occur.
- Mitigation Strategy Design: Creating specific protocols to address each identified risk, which might include specialized sterilization methods, unique inoculation techniques, or enhanced environmental controls.
- Pilot Testing and Refinement: Conducting small-scale trials of the custom procedures, meticulously monitoring for contamination, and refining the protocols based on the results.
Potential Contamination Risks Associated with Specific Mushroom Species
Different mushroom species possess varying susceptibilities to particular contaminants due to their unique growth requirements and genetic makeup. Understanding these species-specific risks allows for targeted preventative measures.
For instance:
- Oyster Mushrooms (Pleurotus spp.): These are generally robust but can be susceptible to green molds (Trichoderma spp.) if introduced during colonization or fruiting stages, especially if substrate moisture is suboptimal.
- Shiitake Mushrooms (Lentinula edodes): Can be prone to bacterial blotch if exposed to excess moisture during fruiting and may also face competition from common molds on sawdust-based substrates.
- Lion’s Mane (Hericium spp.): Known to be sensitive to bacterial contamination, which can manifest as slimy or discolored mycelial growth. Maintaining low humidity and good air exchange is crucial.
- Psilocybe cubensis: While relatively easy to cultivate, they are highly susceptible to common molds like Trichoderma and Penicillium, as well as bacterial contaminants, especially on nutrient-rich substrates.
It is imperative to research the specific contamination challenges associated with any chosen mushroom species before commencing cultivation.
Comparison of Different Types of Air Filtration Systems for Cultivation Spaces
The choice of air filtration system is critical for maintaining a contaminant-free environment. Different systems offer varying levels of filtration efficiency and are suited for different scales and budgets.
The following table provides a comparison of common air filtration systems used in mushroom cultivation:
| Filtration System | Description | Primary Application | Pros | Cons |
|---|---|---|---|---|
| HEPA Filters | High-Efficiency Particulate Air filters capture at least 99.97% of airborne particles 0.3 micrometers in diameter. | Laminar flow hoods, clean rooms, HVAC systems for critical zones. | Extremely effective at removing fine particulates like mold spores and bacteria. | Can be expensive, require regular replacement, and can reduce airflow if not properly integrated. |
| Activated Carbon Filters | Utilize activated carbon to adsorb odors, volatile organic compounds (VOCs), and some gaseous contaminants. | Often used in conjunction with HEPA filters to remove odors and gases that HEPA filters cannot capture. | Effective for odor control and removal of specific gaseous pollutants. | Do not remove particulate matter; have a finite lifespan and require replacement. |
| Pre-filters (e.g., MERV rated) | Basic filters that capture larger particles like dust, lint, and hair. | First stage of filtration in multi-stage systems, protecting more expensive filters from premature clogging. | Inexpensive, extend the life of higher-efficiency filters. | Low filtration efficiency for microscopic contaminants like spores and bacteria. |
| UV-C Sterilization Units | Use ultraviolet germicidal irradiation to kill or inactivate airborne microorganisms. | Can be integrated into HVAC systems or used as standalone units to supplement other filtration methods. | Effective against bacteria, viruses, and mold spores. | Does not remove particulate matter; effectiveness can be reduced by dust and organic matter buildup on the bulb; requires bulb replacement. |
Final Wrap-Up

In conclusion, a proactive and meticulous approach to hygiene, sterilization, and environmental control is paramount in the pursuit of successful mushroom cultivation. By diligently applying the strategies discussed, from understanding contaminant types to employing advanced prevention techniques, cultivators can significantly mitigate risks and foster an optimal environment for fungal growth. Embracing these best practices not only leads to healthier yields but also cultivates a deeper appreciation for the delicate balance required in this rewarding endeavor.